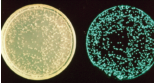
发光细菌

欢迎访问湖南碧霄环境科技有限公司官方网站!
发光细菌 luminescent bacteria.luminousbacteria,进行生物发光的细菌。多数为海生,与发光浮游生物同能引起海面发光。此外,在空气中,死鱼及水产加工食品的表面于暗处也会发光,这种发光现象导致海生菌的第二次生长繁殖。用加有3%NaCl,1%甘油的普通肉汁蛋白胨培养基可以培养。发光菌形态虽多种多样,但生理特性却非常相似。一般对明胶不产生液化,分解蛋白质后不形成毒物,常寄生在各种动物体上引起“发光病”,即寄生发光。这些细菌通常经由寄主的卵传递给后代寄主。有些发光鱼类和乌贼是和发光细菌共生而利用了细菌的发光。明亮发光杆菌(Photobacterium phosphoreum)可在牛马的死尸和肉中繁殖;它侵入人体则会产生发光尿。这些细菌一般好低温,最适温度约为18℃,37℃以上则不发光。发光现象是酶促氧化反应,必需FM-NH2,O2长链饱和醛,虫荧光素酶等。一般认为FMNH2就是荧光素。发光细菌有一百几十种,除上述几种外,典型的还有鱼无色杆菌(Achromobac-ter fisheri)、磷光弧菌(Vibrio phosphoresce-ns)、发光杆菌(Bacillus photogenus)等。细菌发光的生物学意义与动物发光不同,还不十分清楚。根据具有可以抑制氯高铁血红素呼吸浓度的一氧化碳或氰化物,而不能抑制其氧化过程这点来看,可以把它看作是不参与细胞色素系统的呼吸形式称为发光呼吸。发光细菌发出青白色光,如鱼无色杆菌所发出的光,波长最长为490纳米。
目前国内常用的3种发光细菌为:明亮发光杆菌、费氏弧菌、青海弧菌。
其中以明亮发光杆菌在 GB/T15441-1995 水质 急性毒性的测定 发光细菌法中所使用;
费氏弧菌在欧盟的标准中所使用;青海弧菌是在青海湖的鱼体内提取的菌种,属淡水菌,在测试饮用水时有较大优势,并已申请冻干粉制作zhuanli:ZL 97106203.X
该检测方法在5.12汶川地震灾区有了较大规模的应用,快速、便捷、综合评价等优点得到了充分发挥,受到了卫生、环保、疾控部门的重视,国家也将其列入应急监测项目。
《发光细菌与环境毒性检测》一书由朱文杰、郑天凌、李伟民三位老师完成的作品,内容主要介绍了发光细菌的发现及应用领域等信息,着重介绍了青海弧菌的发展过程,大家感兴趣的话可以进行查阅!